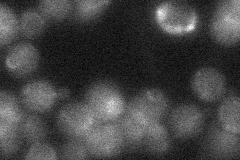
YPL092W
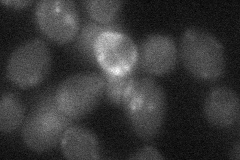
YPL092W
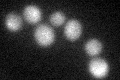
YPL092W

View description
Plasma membrane sulfite pump involved in sulfite metabolism and required for efficient sulfite efflux; major facilitator superfamily protein
Localization:
Intensity:
Fold change:
Significance:
-
C’ GFP library in SD

below threshold14.84 -
N' NOP1pr-GFP in SD

cell periphery,ER37.9314 -
N' TEF2pr-mCherry in SD

ER13.7172 -
N' NATIVEpr-GFP in SD
below threshold21.8145 -
N' TEF2pr-VC and Cyto-VN in SD
below threshold21.6408 -
C’ GFP library in SD+DTT
cytosol15.211.02No -
C’ GFP library in SD+H2O2

cytosol14.720.99No -
C’ GFP library in Starvation Media

cytosol16.821.13No -
C’ GFP library on the background of Pup2-DaMP

below threshold -
C’ GFP library on the background of CCT mutant

below threshold15.23131.02574No
